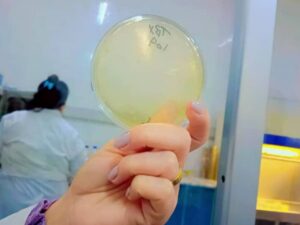

The Faculty of Science at Homs University has organized a scietific visit to the Directorate of Supply and Internal Trade for the master’s students in biotechnology under the supervision of Prof. Zainab Al-Halwani, within the framework of the university’s academic orientation towards promoting interactive education and linking the theoretical aspect with practical application.
The visit aimed to learn about the mechanisms for analyzing food samples and about the laboratory equipment used in the directorate’s departments, in order to contribute to developing the students’ practical skills and enhancing their practical understanding of the concepts of quality and food safety.
The tour included a visit to a number of specialized departments, where the technical staff in the directorate provided a comprehensive explanation of the approved analysis methods and answered the students’ inquiries, which added an enriching interactive character to the visit.
The students were accompanied on the tour by:
- Mr. Wael Barghal, Director of Internal Trade and Consumer Protection in Homs,
- Eng. Aisha Habos, Head of Technical Affairs, Quality and Intelligence,
- Eng. Nihad Assaf, Head of the Food Analysis Department,
- Eng. Diana Khuzam, Head of the Microbiological Analysis Department,
- Eng. Rafah Mulla Ali, PCR Department.
This visit is part of a series of scientific activities organized by the faculty with the aim of enabling students to gain practical experience and enhance their readiness for the labor market in the fields of biotechnology and laboratory analysis.